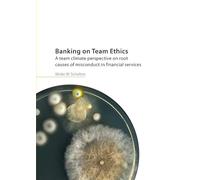
Banking on Team Ethics: A team climate perspective on root causes of misconduct in financial services

£14.56
Amazon-marketplace.co.uk
Delivery from £19.88

£11.75
Amazon-marketplace.co.uk
Delivery from £2.80

£24.19
amazon.co.uk
Free Delivery

£31.99
amazon.co.uk
Free Delivery

£15.67
Amazon-marketplace.co.uk
Delivery from £4.10

Financial Markets, Climate Risk and Renewables: Conference on Pathways to Sustainable Economy-A Banking and Finance Perspective (SEBF), IIT Bombay, ... Proceedings in Business and Economics)
£155.83
amazon.co.uk
Free Delivery

£28.17
Amazon-marketplace.co.uk
Delivery from £2.80

Banking on a Human Scale
£8.05
amazon.co.uk
Delivery from £2.99

Banking on America: How TD Bank Rose to the Top and Took on the U.S.A.
£15.96
Amazon-marketplace.co.uk
Delivery from £7.74

£15.99
amazon.co.uk
Free Delivery

£13.99
amazon.co.uk
Free Delivery

£40.00
amazon.co.uk
Free Delivery

£104.39
Amazon-marketplace.co.uk
Free Delivery

£67.73
Amazon-marketplace.co.uk
Free Delivery

£84.00
amazon.co.uk
Free Delivery

£62.78
Amazon-marketplace.co.uk
Free Delivery

£18.96
Amazon-marketplace.co.uk
Delivery from £4.37

£39.00
amazon.co.uk
Free Delivery

£14.74
Amazon-marketplace.co.uk
Delivery from £4.02

£41.00
amazon.co.uk
Free Delivery
Banking on Team Ethics: A team climate perspective on root causes of misconduct in financial services
£32.50
Amazon-marketplace.co.uk
Delivery from £2.80

Procedural narratives on violence in banking work: A social constructionist approach
£43.00
amazon.co.uk
Free Delivery

£15.03
ebay.co.uk
Free Delivery

THE WORLD BUILT ON CREDIT: A Plain-English Guide to Fractional Reserve Banking, Debt Expansion, and How Modern Economies Grow
£4.44
amazon.co.uk
Delivery from £2.99

£16.00
Whsmith.co.uk
Delivery from £3.99

Breaking Into Banking: Cracking the Code on Launching a Successful Career in Commercial Banking
£9.91
amazon.co.uk
Delivery from £2.99

The High-5 Banking Method : A Money System You Can Count On
£20.90
Whsmith.co.uk
Delivery from £3.99

Finance Terminology Crossword Puzzle Book: 50 Challenging Puzzles on Investing, Banking, Markets & Economics for Students & Professionals - A Smart Gift Idea (MajorPuzzles Series)
£7.99
amazon.co.uk
Delivery from £2.99

£9.74
amazon.co.uk
Delivery from £2.99

Large Language Models in Finance: A hands-on guide to applying Large Language Models in trading, banking, risk & financial compliance
£37.99
amazon.co.uk
Free Delivery

£71.25
Whsmith.co.uk
Free Delivery

£53.00
amazon.co.uk
Free Delivery

£33.00
Amazon-marketplace.co.uk
Free Delivery

A Text Book on Money Banking
£8.52
amazon.co.uk
Delivery from £2.99

Creating a New One Dollar Coin (S. 874): Hearing Before the Committee on Banking, Housing, and Urban Affairs, United States Senate, One Hundred Fourth ... and Circulation of One Dollar Coins, and F
£8.63
Amazon-marketplace.co.uk
Delivery from £3.99

£53.19
Whsmith.co.uk
Free Delivery
![Banking [on] Blockchain: A Legal and Regulatory Primer](https://cdn.pricehunter.co.uk/offer/en/banking-on-blockchain-a-legal-and-regulatory-primer-200t180d355aeb7d895bc12e9f15f31a48229a9a5ac2998.jpg)
Banking [on] Blockchain: A Legal and Regulatory Primer
£63.97
Amazon-marketplace.co.uk
Delivery from £7.74

Banking on the Truth: A Ruby Finch Mystery: 2 (Ruby Finch Mystery Series)
£14.90
amazon.co.uk
Free Delivery

Pratts' Manual of Banking Law: A Treatise on the Law Applicable to the Every-Day Business of Banks
£10.95
amazon.co.uk
Free Delivery

£11.42
amazon.co.uk
Free Delivery
- 1
- 2
- 3
- 4
- 5
- next page
🤖 Ask ChatGPT
🛍️ What are the most important purchase criteria?
💰 Tell me the best deals!
📋 Create a short summary!
Informations about "banking on a"
Compare 819 offers for your search.
Pricehunter was able to locate products in 21 categories, ranging from £2.19 to £809.06.
About "banking on a"
- In total, Pricehunter was able to locate 15 offers, from web-shops such as Amazon-marketplace.co.uk, blitzhandel24.de (UK), vrsoft.co.uk and bluenandu.uk.
- After having chosen your supplier you may also choose the delivery company. 14 delivery companies are available Oxford University Press, Parker Games, Wiley-VCH and Cambridge University Press being the most popular.
- The most offers (62) were found in the price range from £12.00 to £12.99.
- Customers who looked for this item also found interesting.
- With our extensive colour palette you can select your favourite colour for your article. Of the available 57 shades White is the most frequently chosen.
Don't forget your voucher code:
Report Illegal Concerns
You are about to report a violation based on the EU Digital Services Act (DSA).